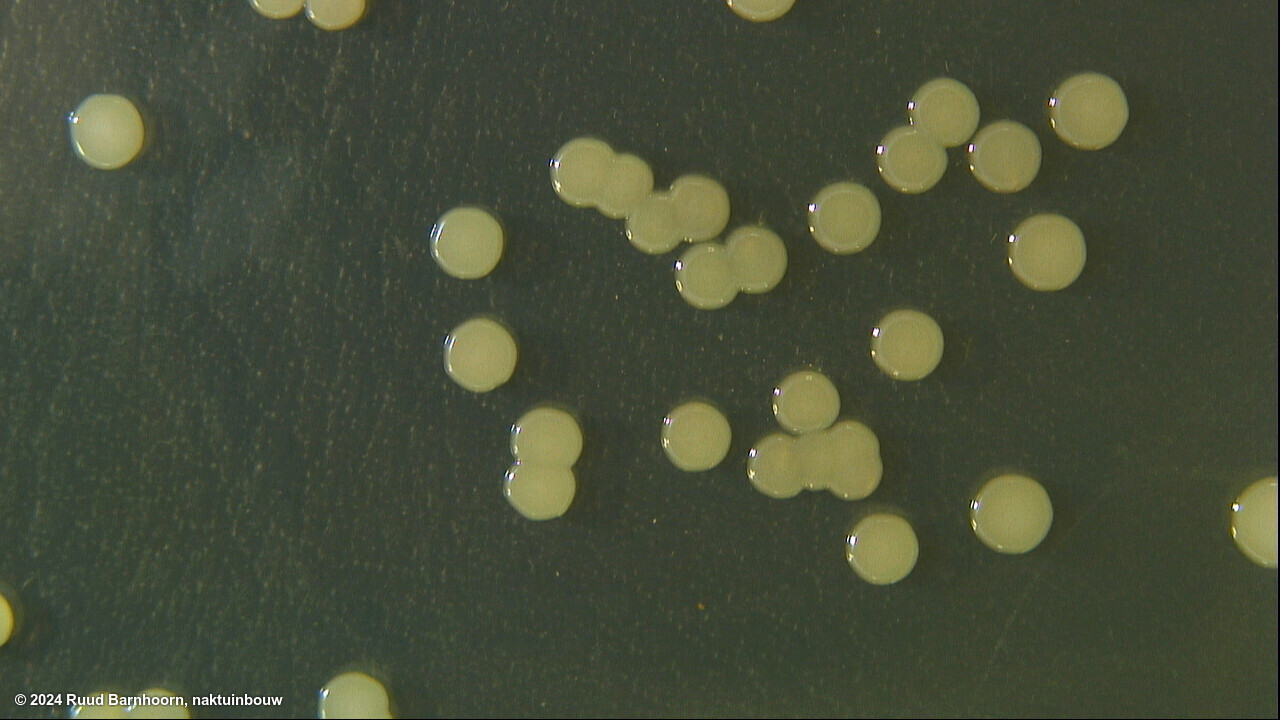
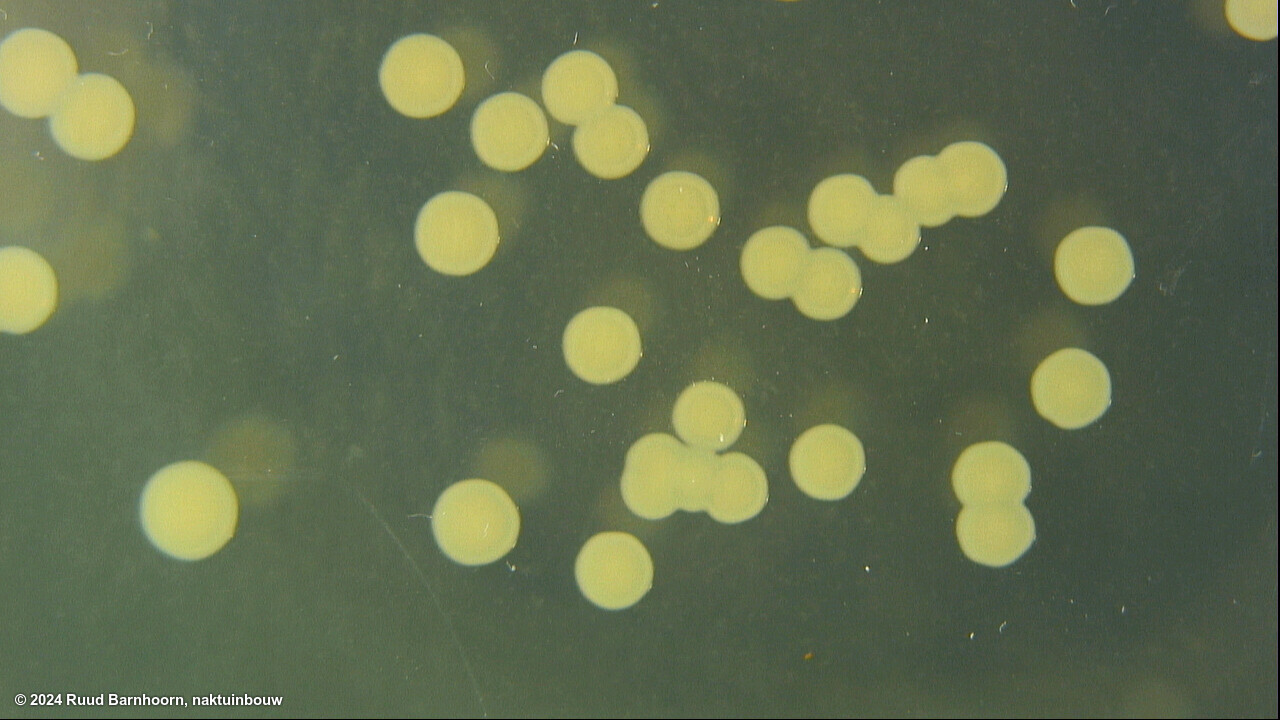
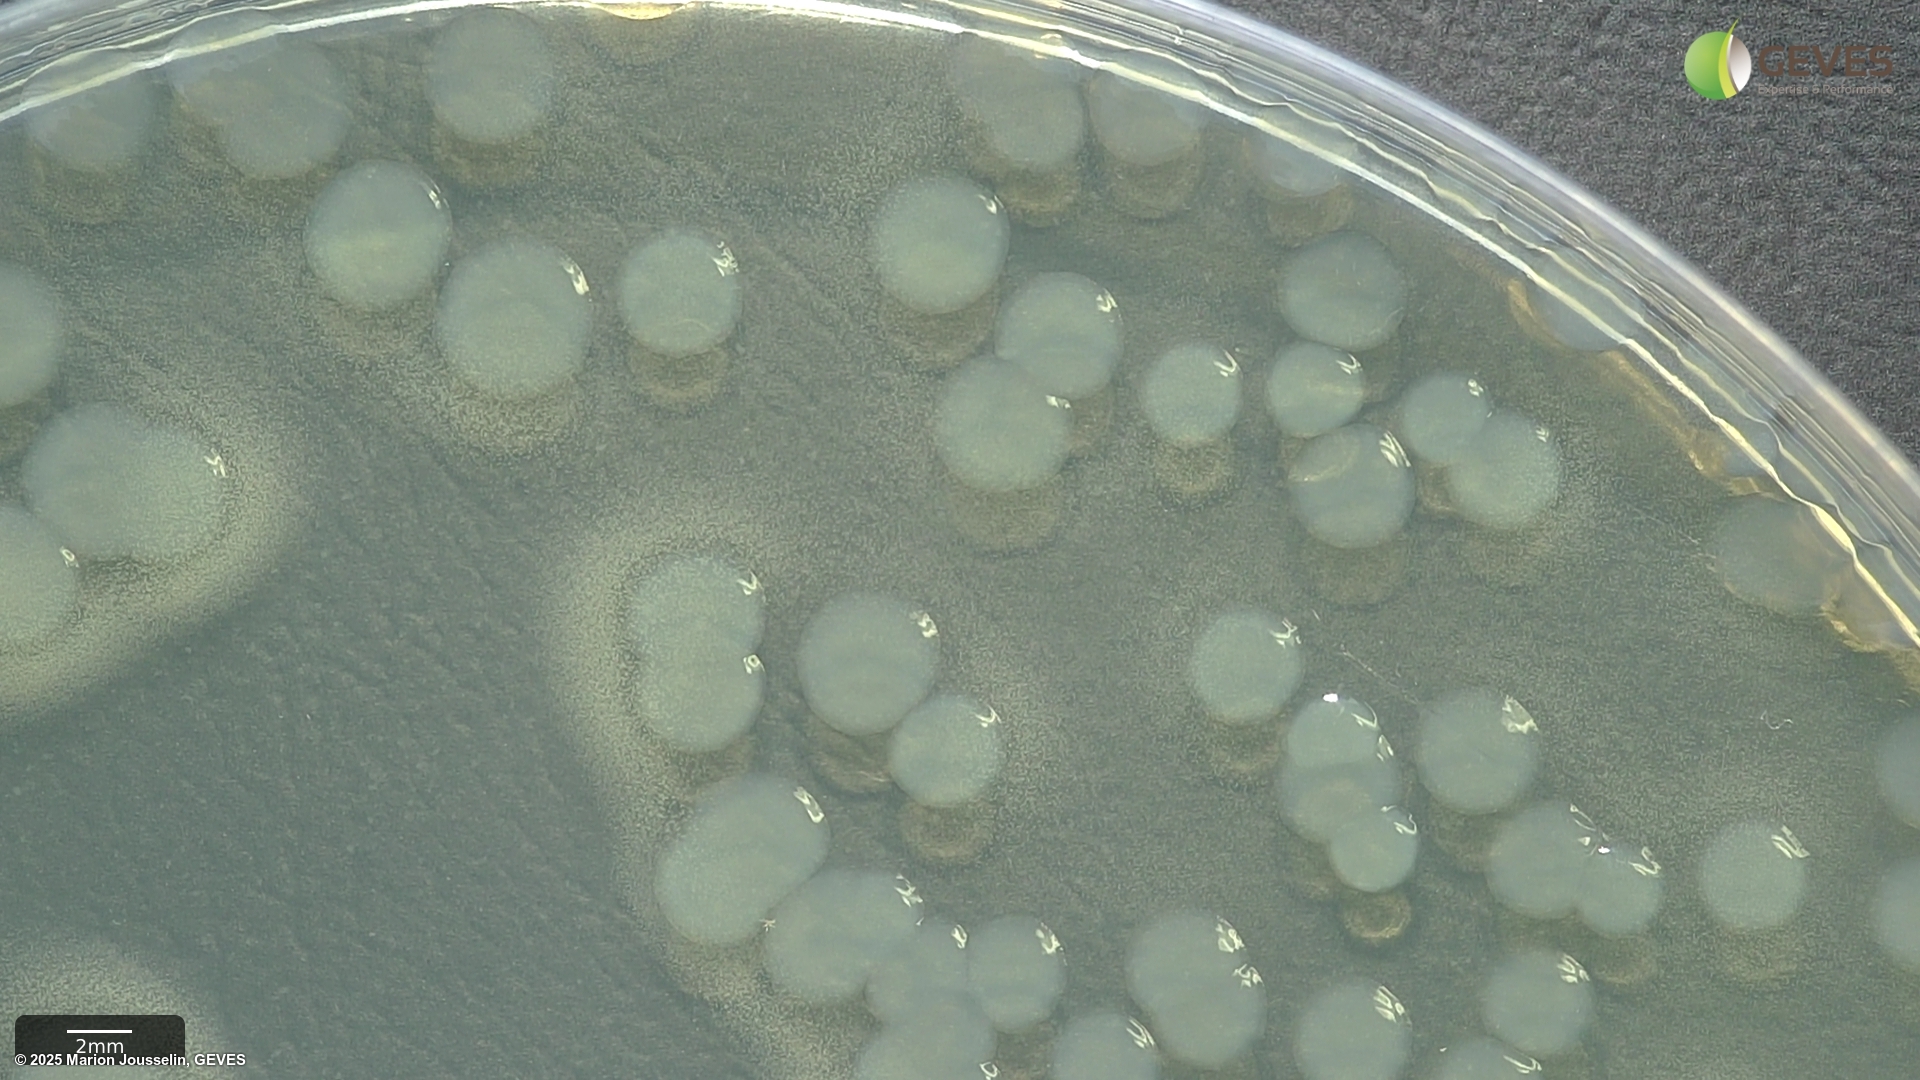
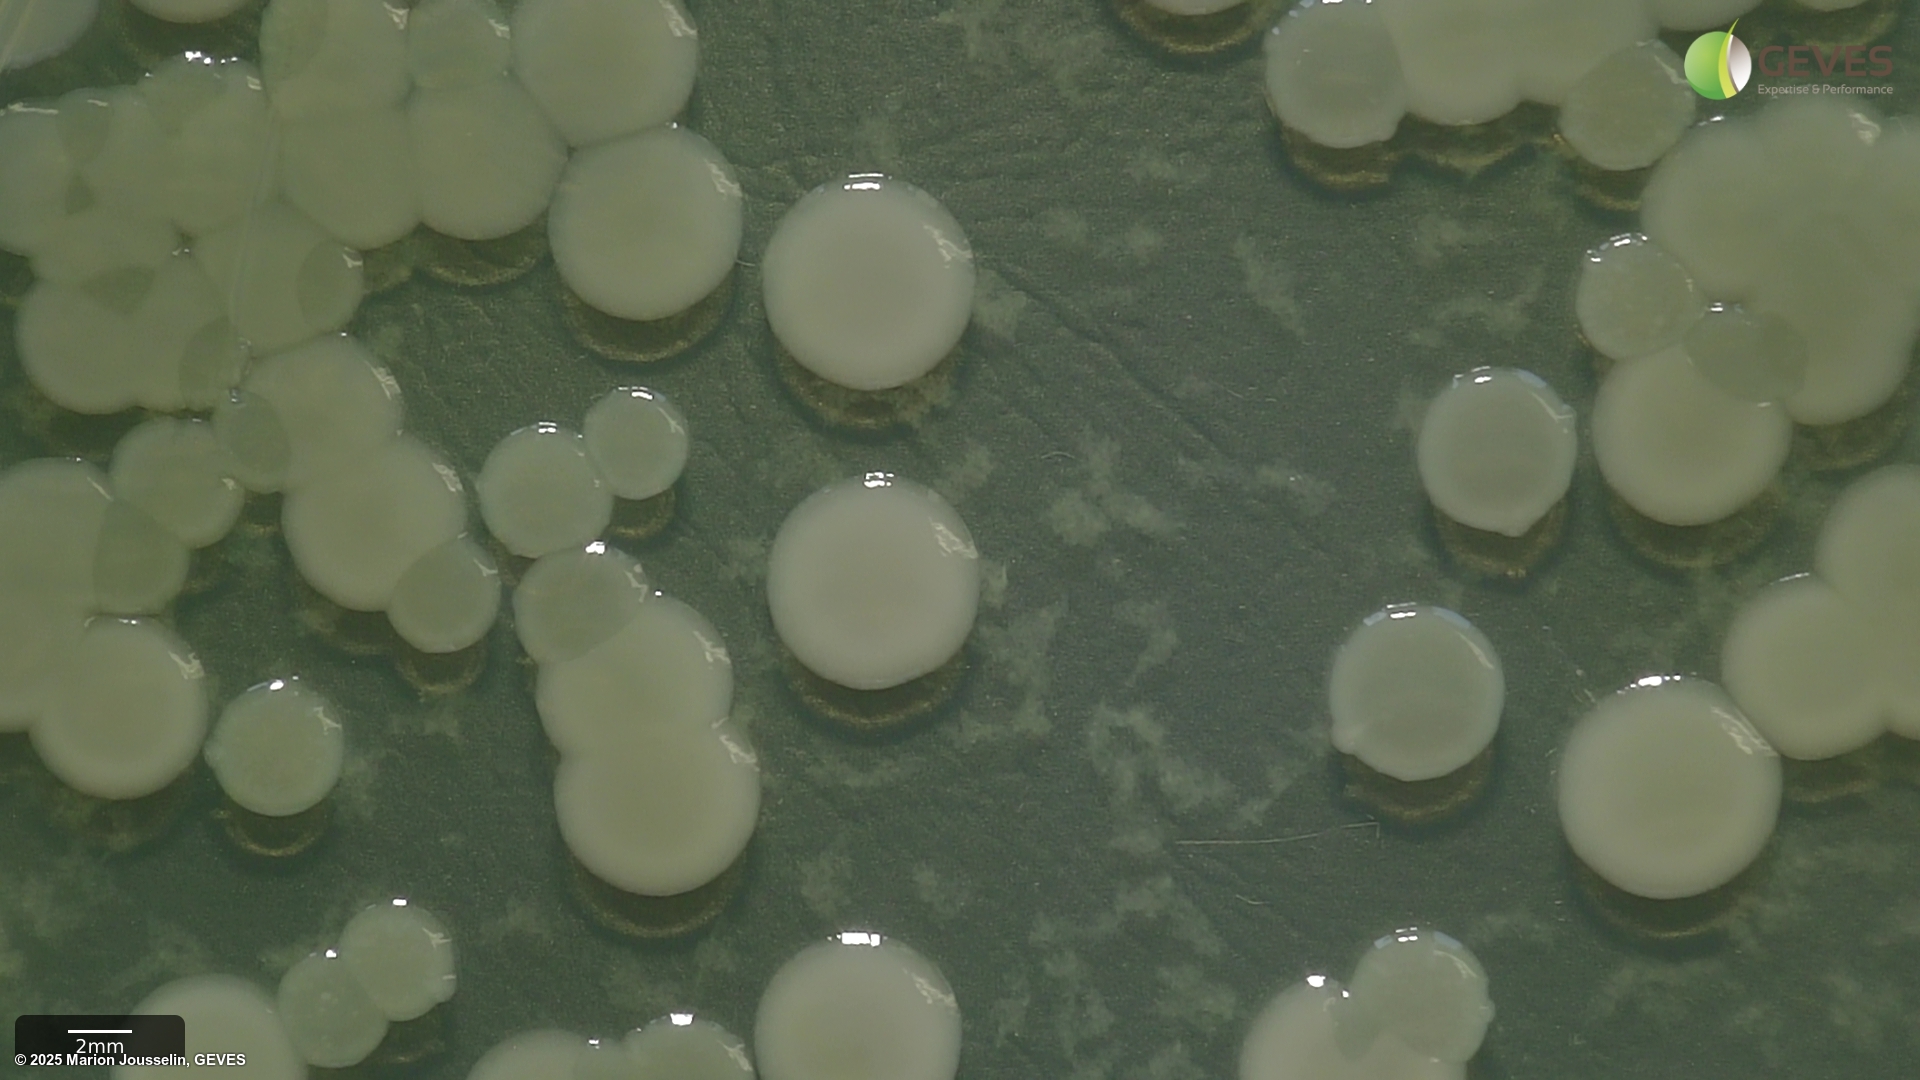

Pathogen
Pseudomonas syringae pv. syringae
Overview
|
Scientific name
|
Pseudomonas syringae pv. syringae |
|
Genus
|
Pseudomonas |
|
EPPO code
|
PSDMSY |
|
Common name
|
Bacterial canker or Leaf spot |
|
Synonyms
|
Pseudomonas syringae pv. japonica |
Description
Confirmed on ISTA Reference Pest List as a seed-borne disease.
This description is a ‘stub’ as ISTA has no previous publications on this pathogen. If you would like to contribute and expand this, please feel free to email us at contact@seedhealthtestimagedb.info